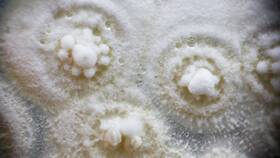

Современные специалисты различных профессий применяют широкий спектр инструментов, технологий и методик для эффективного выполнения своих обязанностей. Рассмотрим основные категории используемых ресурсов.
Содержание
Основные инструменты и ресурсы
- Техническое оснащение - компьютеры, специализированное оборудование
- Программное обеспечение - профессиональные программы и приложения
- Информационные источники - базы данных, нормативные документы
- Коммуникационные средства - почта, мессенджеры, видеосвязь
Примеры инструментов по профессиям
| Профессия | Основные инструменты | Специализированное ПО |
| Бухгалтер | Калькулятор, налоговые справочники | 1С:Бухгалтерия, Контур.Эльба |
| Дизайнер | Графические планшеты, цветовые палитры | Adobe Photoshop, Figma, CorelDRAW |
| Программист | Системы контроля версий, фреймворки | Visual Studio, Git, Docker |
Критерии выбора рабочих инструментов
- Соответствие профессиональным задачам
- Удобство и эргономичность использования
- Совместимость с другими системами
- Стоимость и условия лицензирования
- Возможности автоматизации рутинных процессов
Тенденции в организации рабочего процесса
Современные специалисты все чаще используют облачные технологии для хранения и обработки данных, мобильные приложения для удаленной работы, системы искусственного интеллекта для анализа информации. Важное значение приобретают инструменты для совместной работы в режиме реального времени и автоматизации повторяющихся задач.